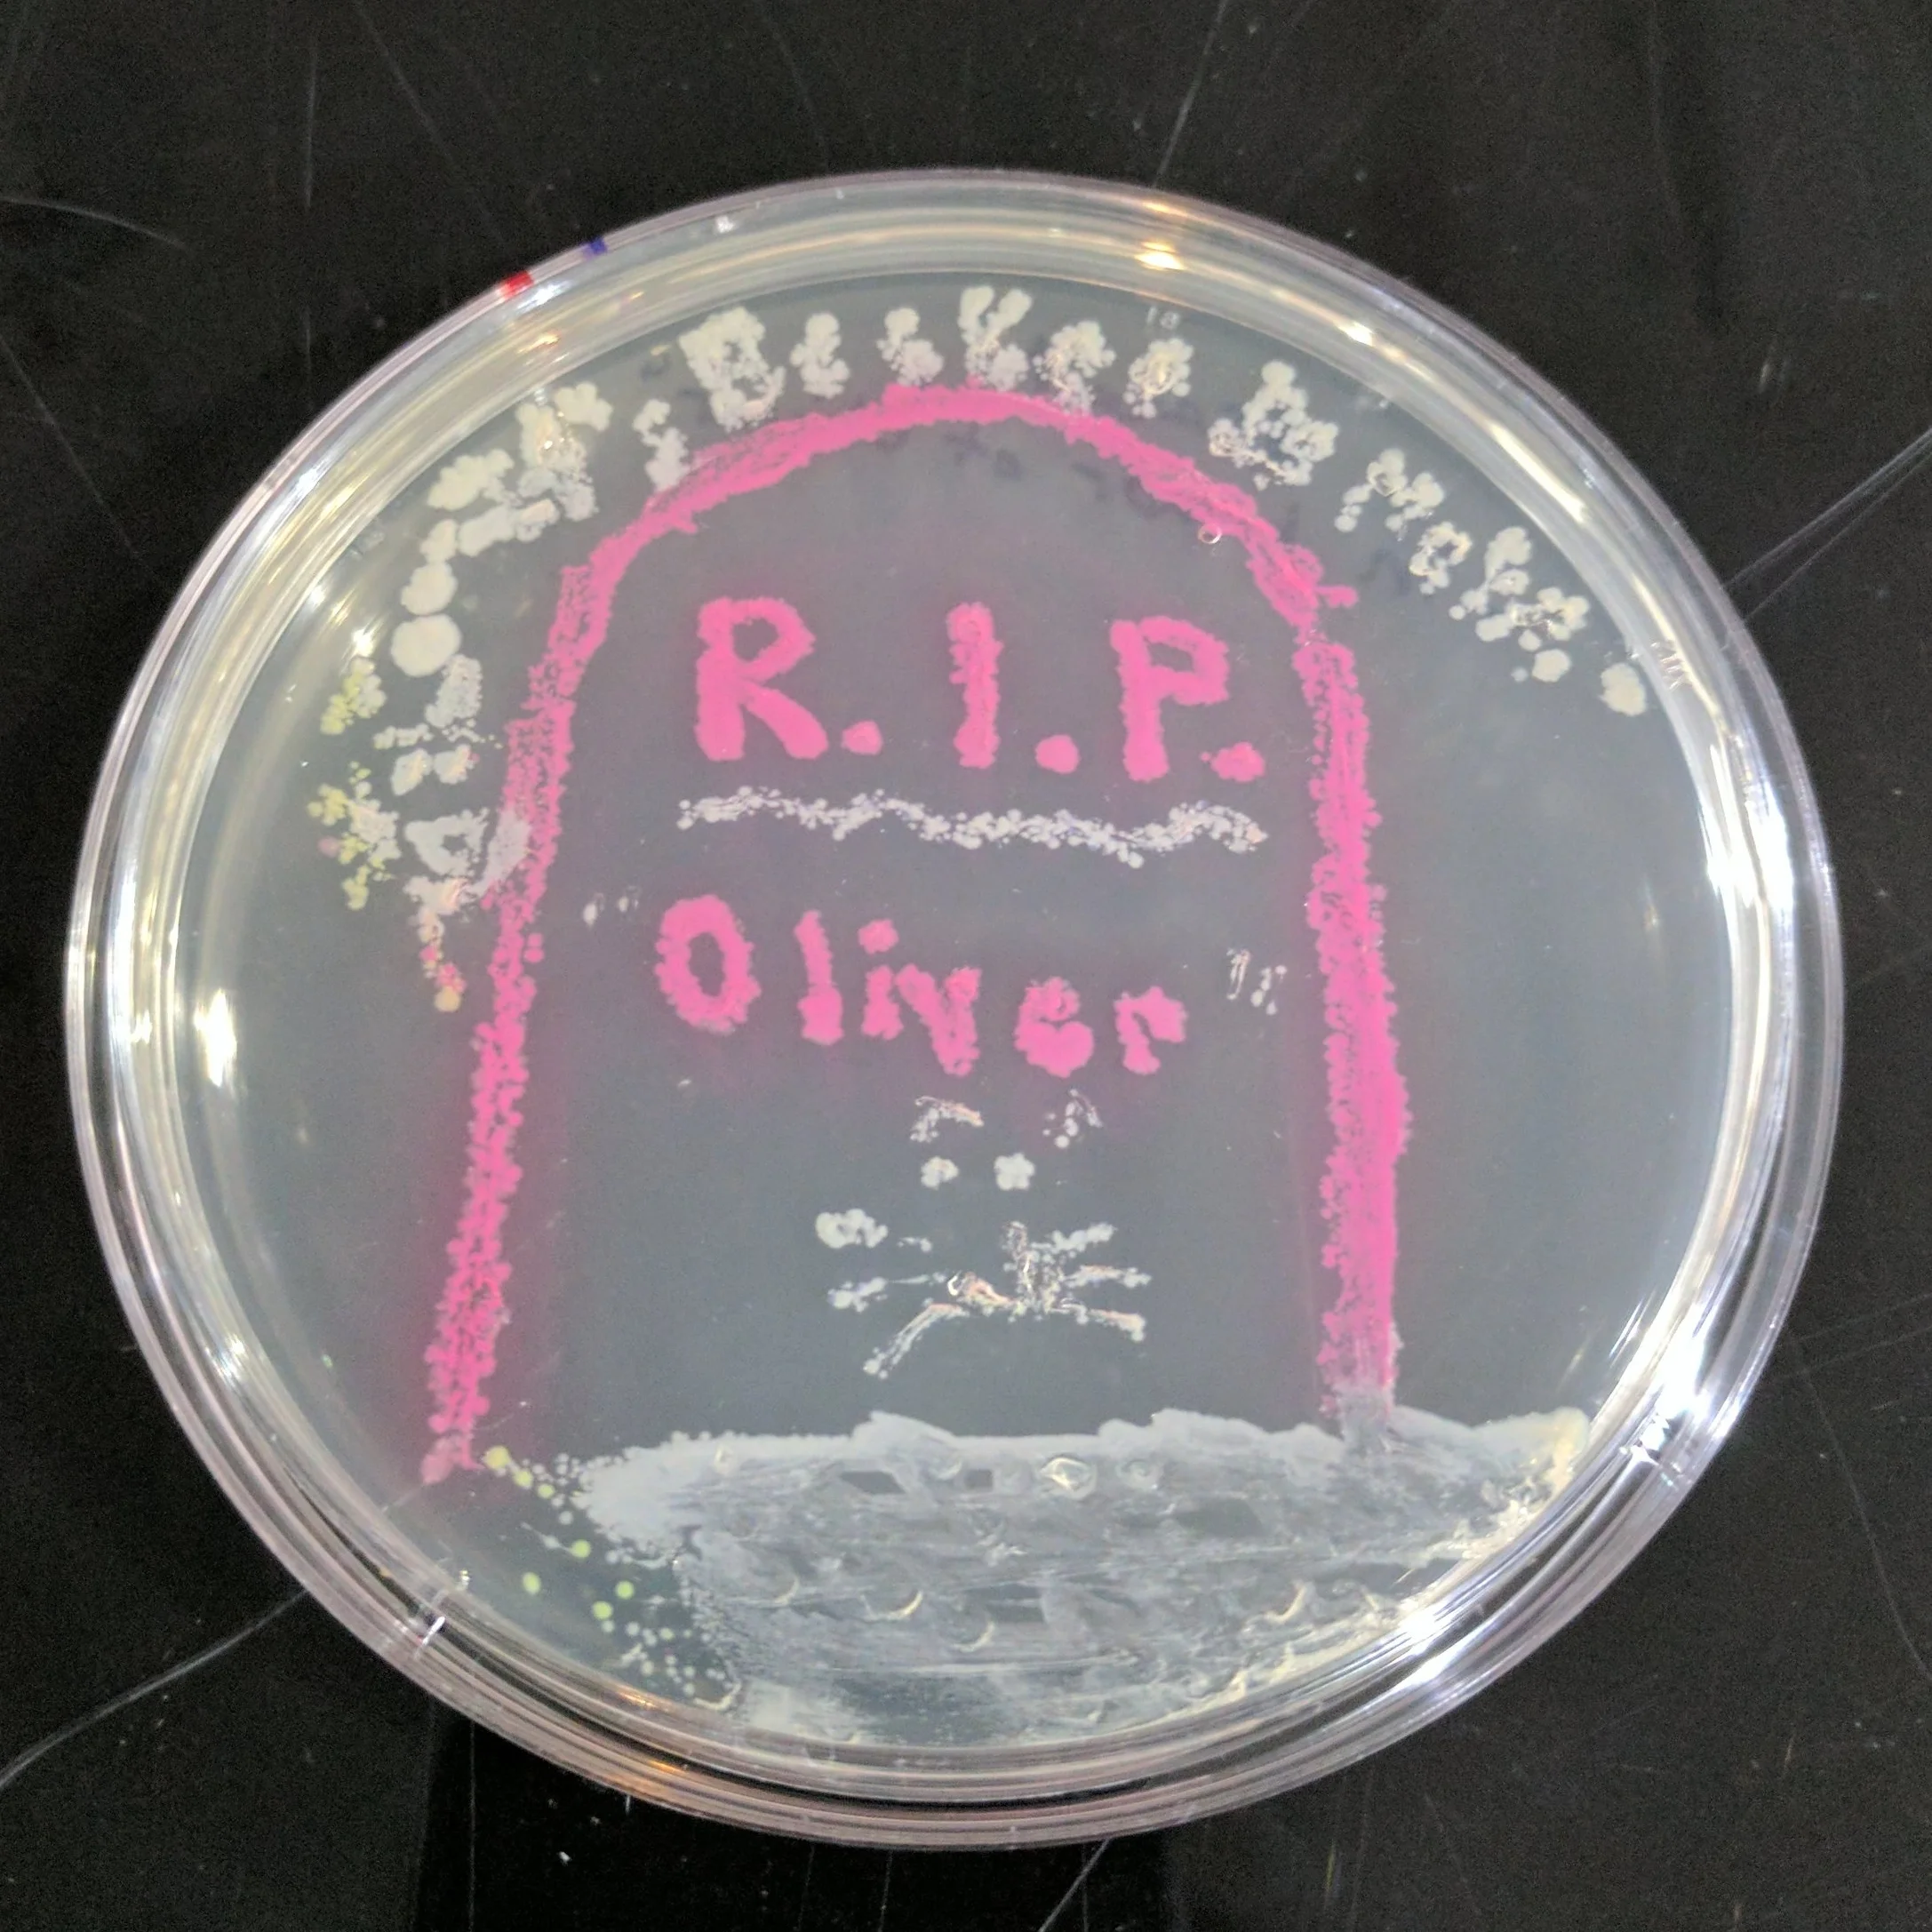
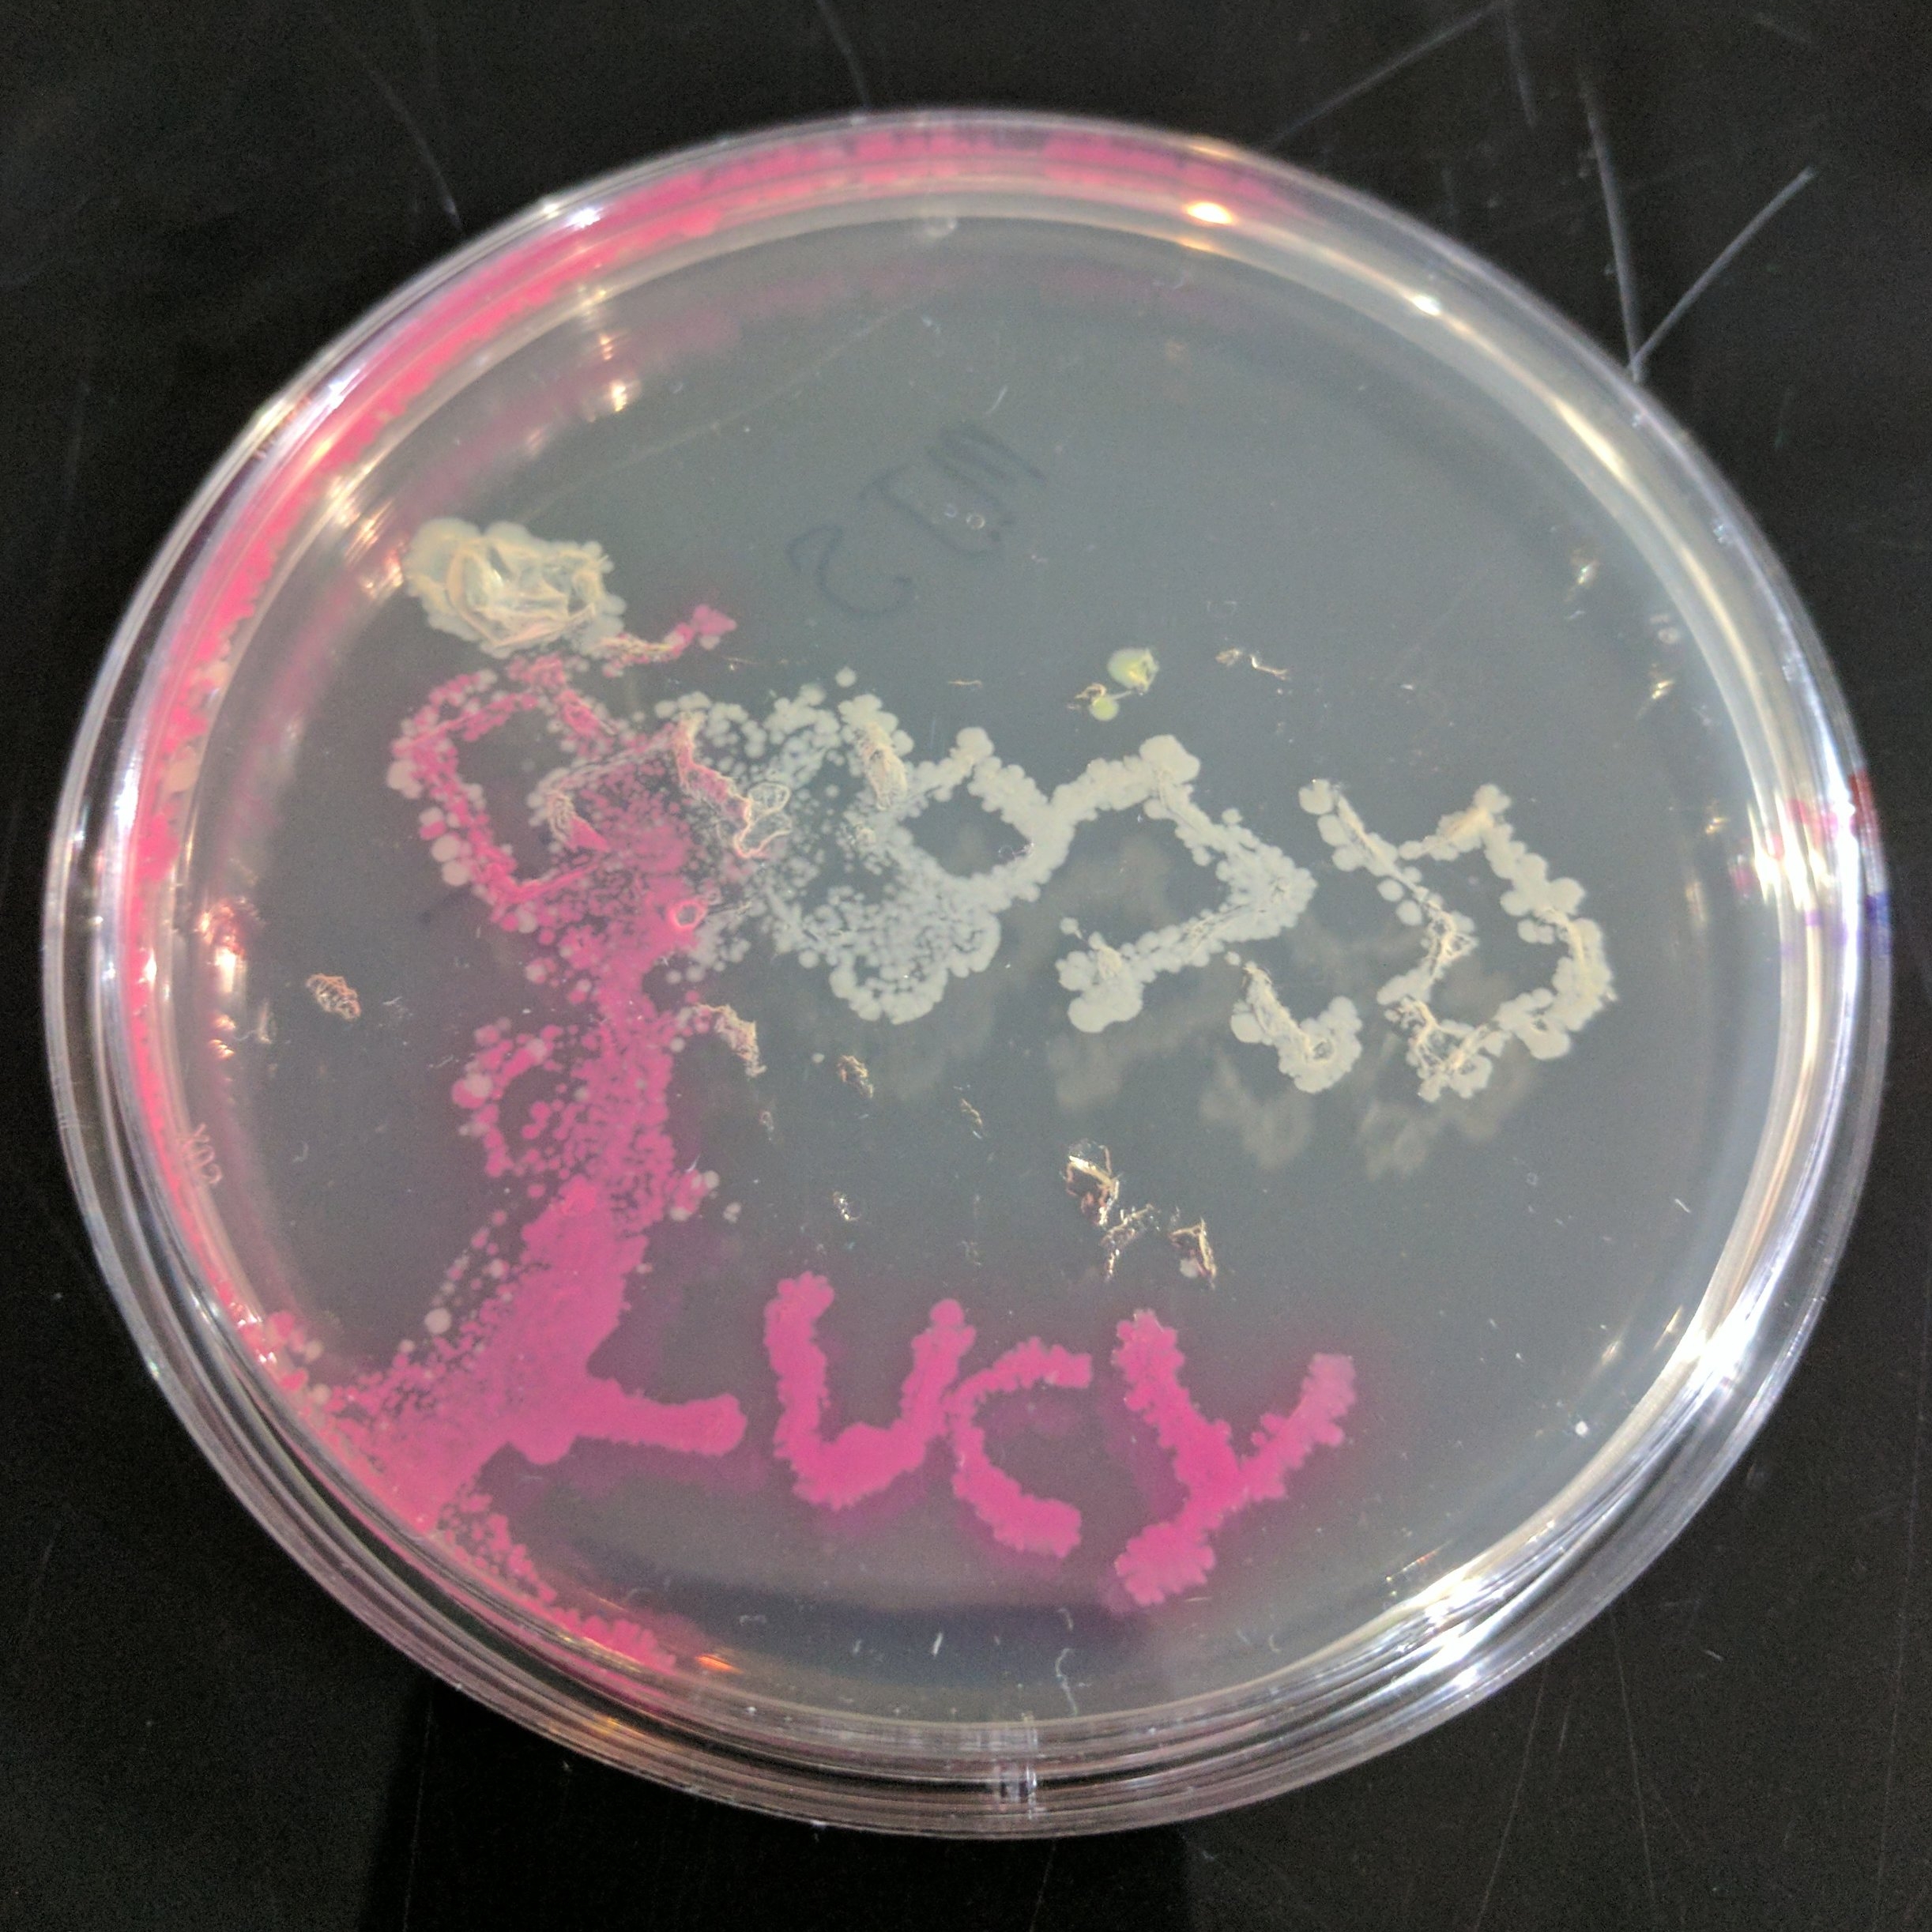
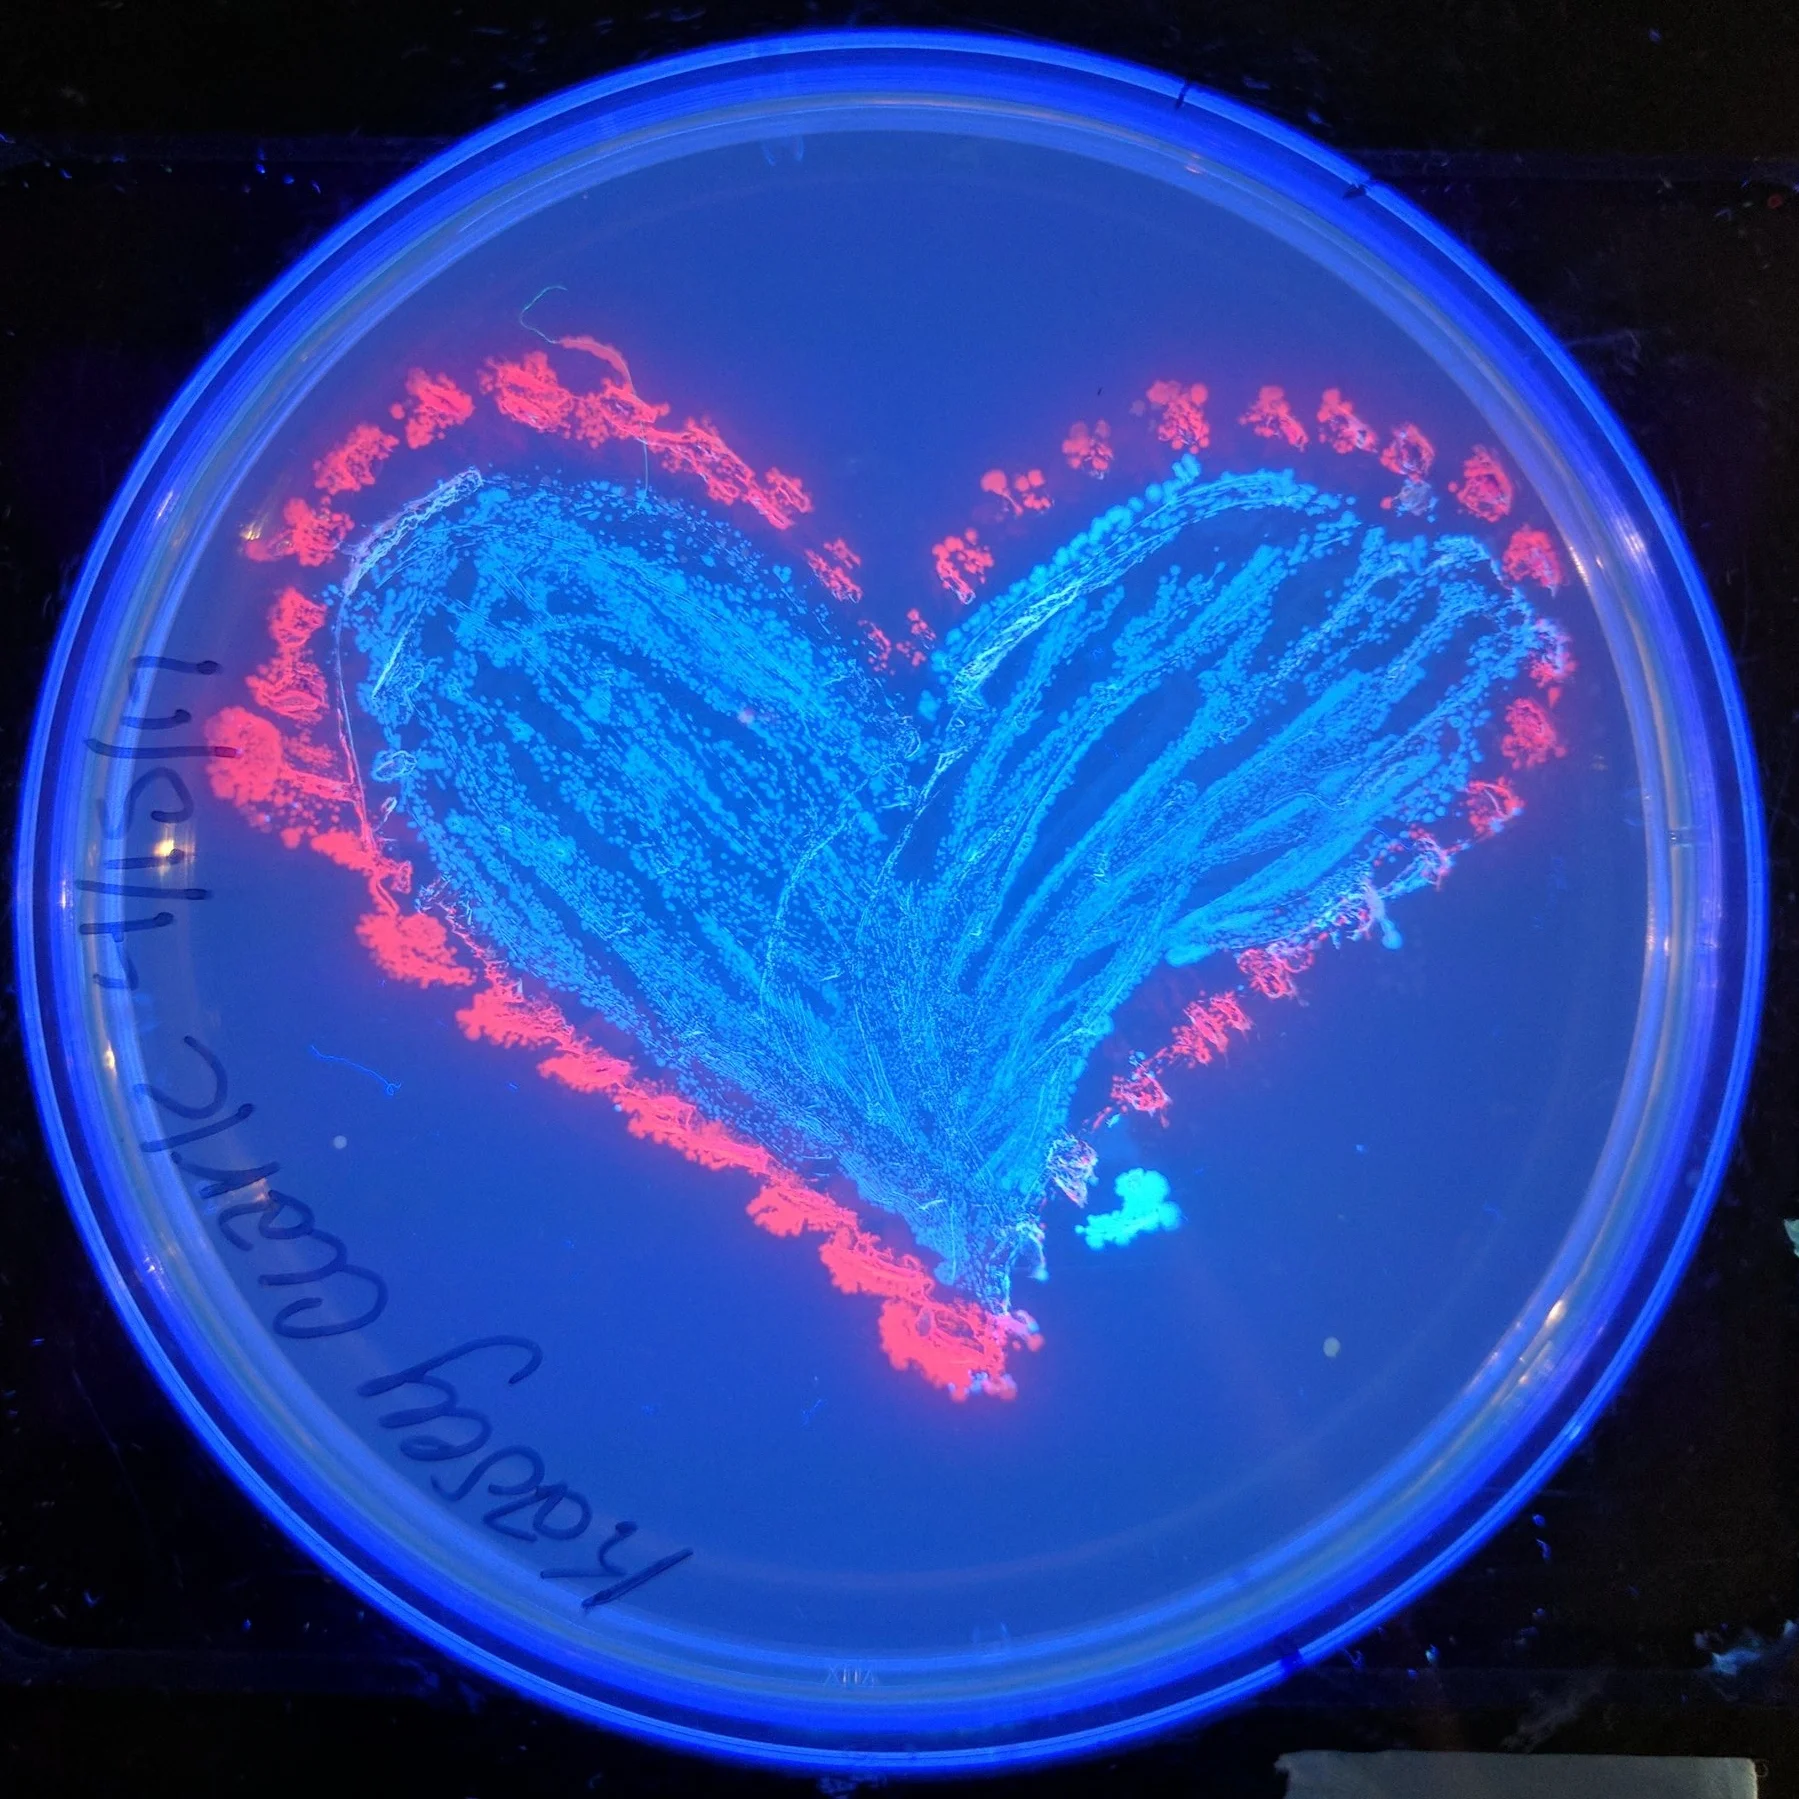
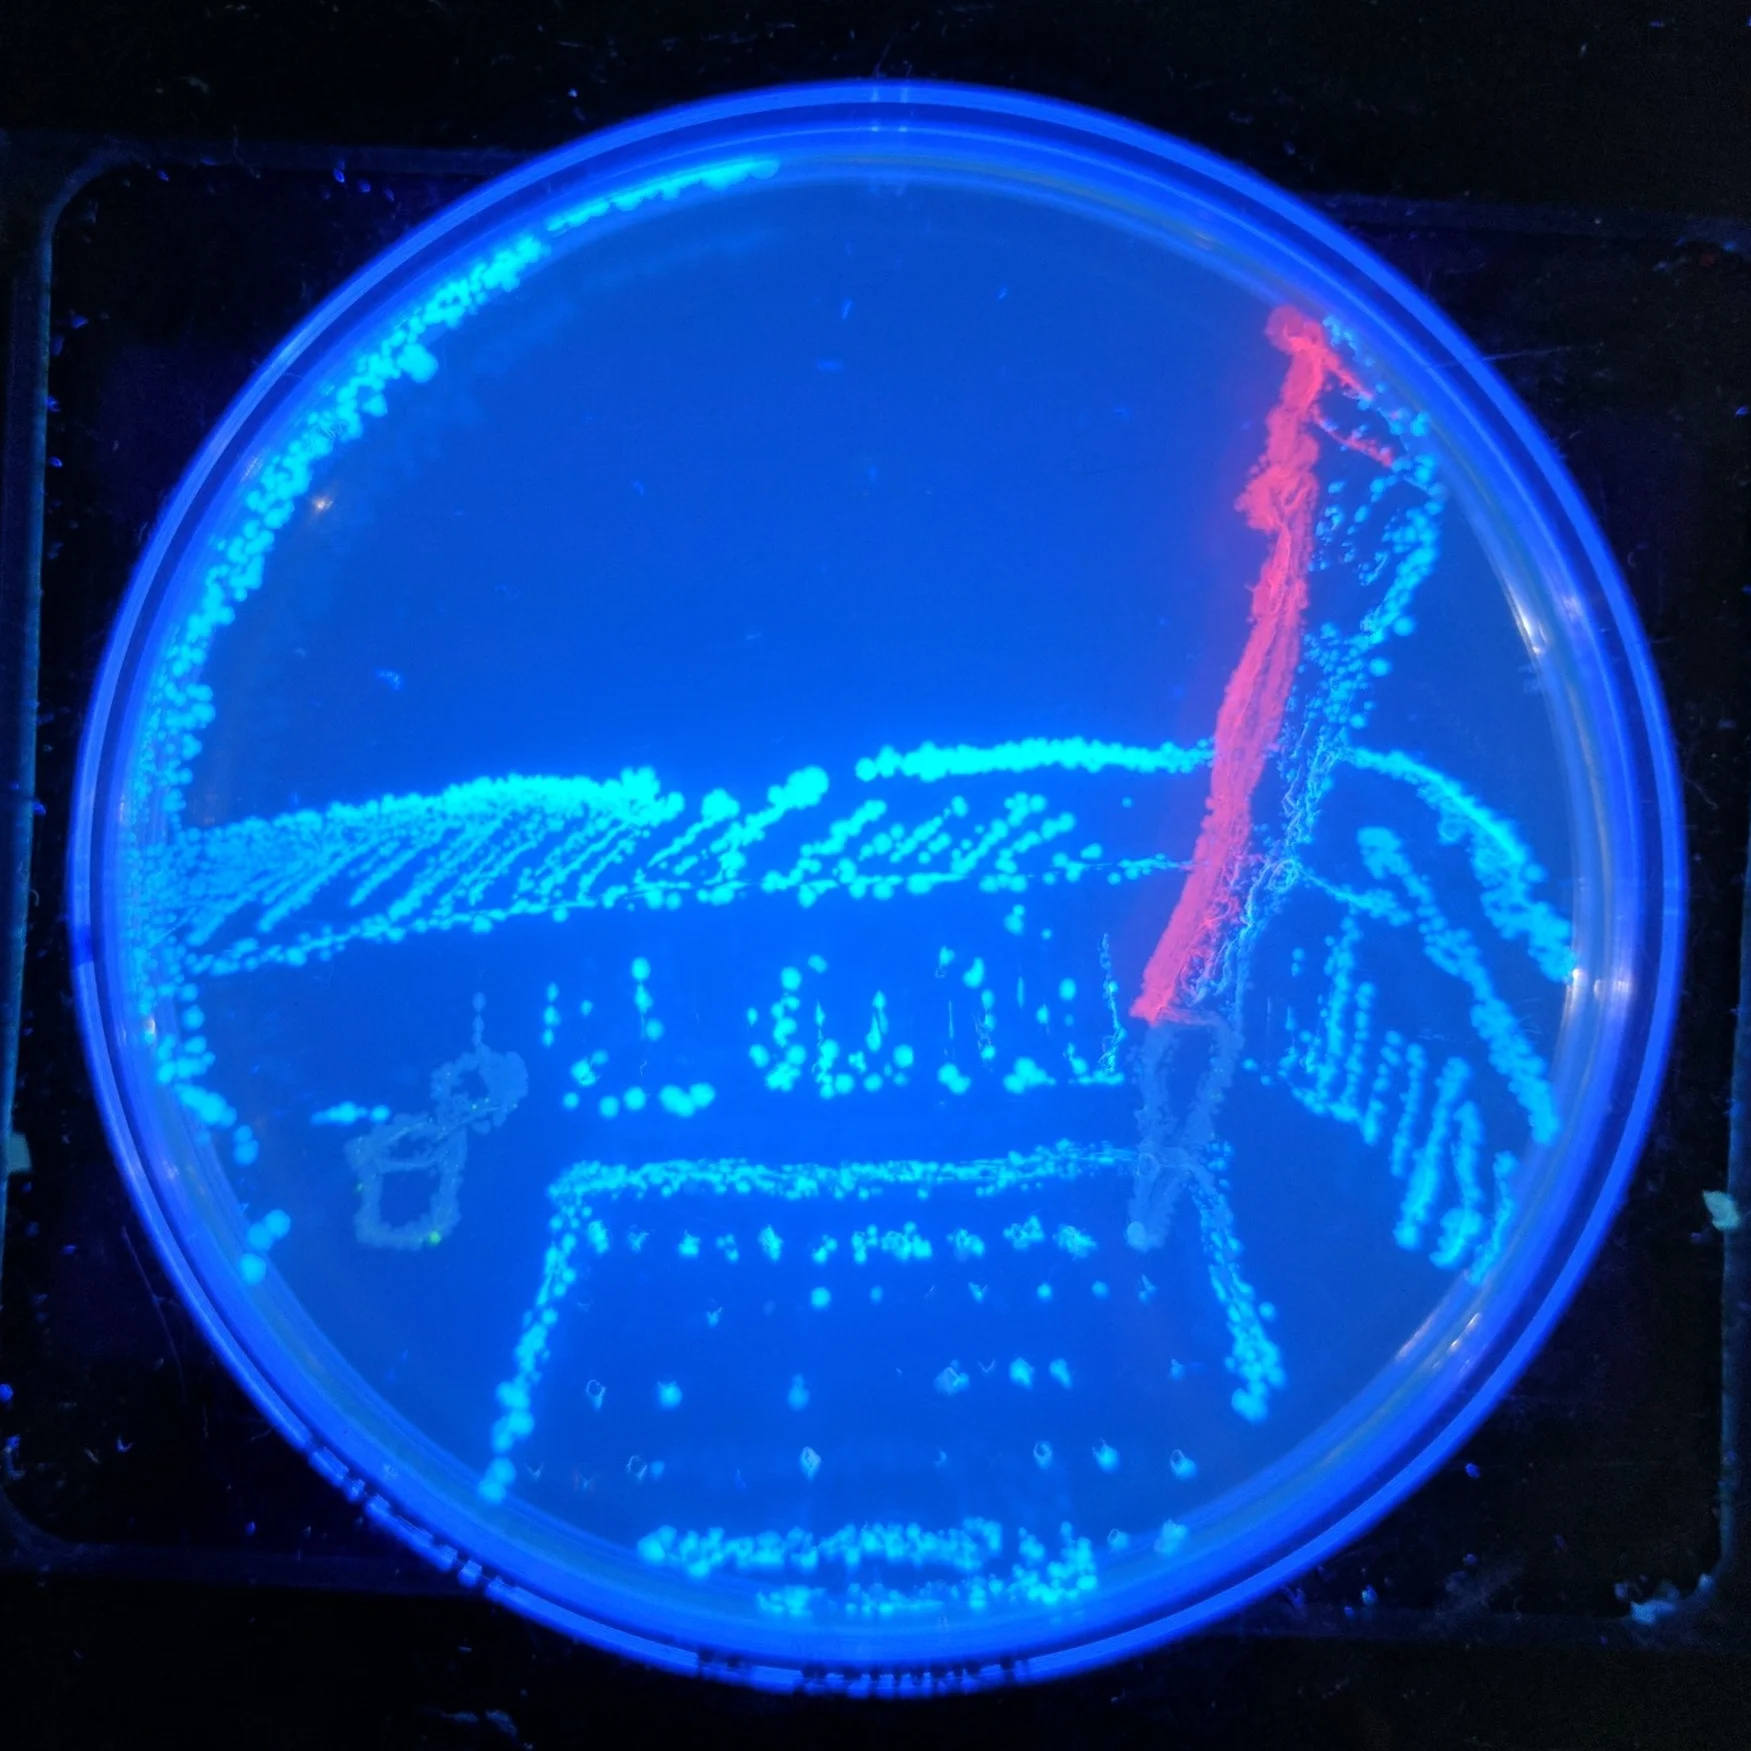
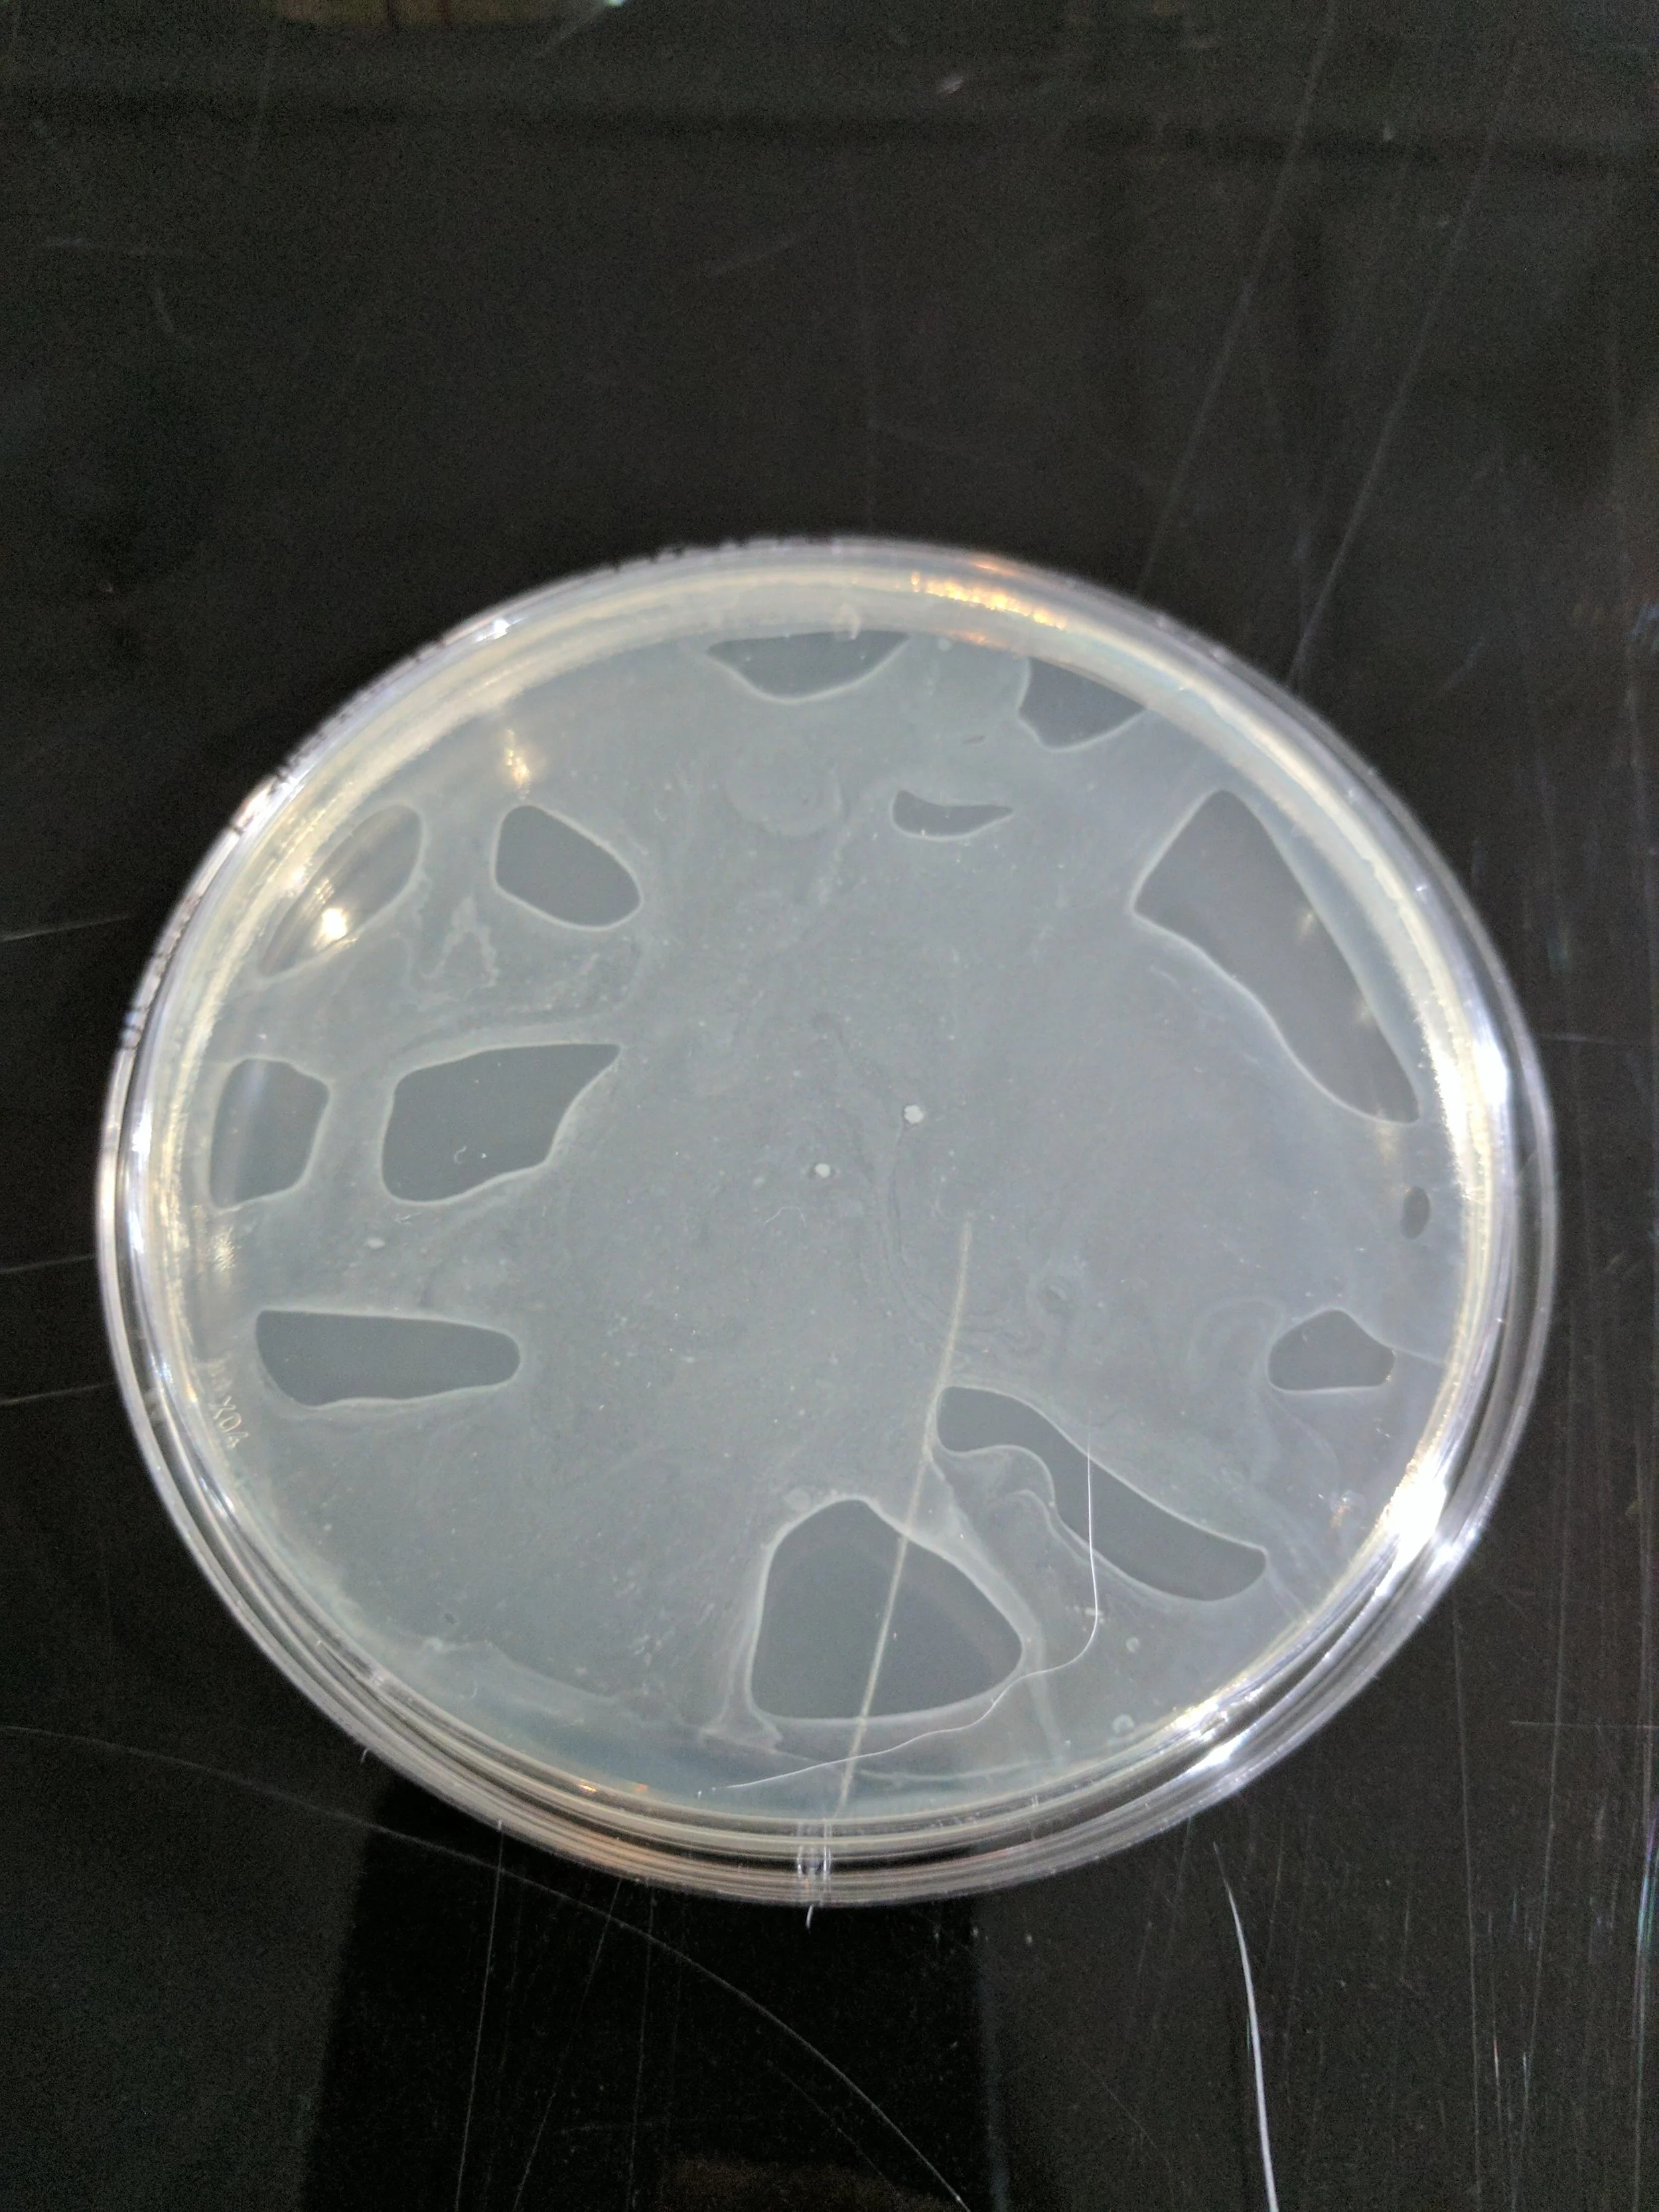
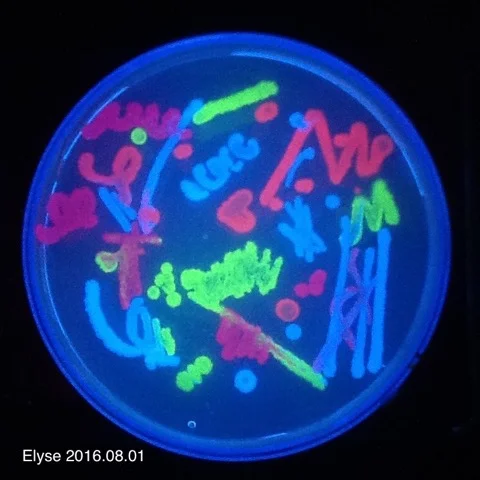

Painting with Bacteria to Celebrate Seattle
For our launch party held on March 11, 2017, we wanted to celebrate our new space in our amazing city. The week prior, we took a trip to Uwajimaya to find some fresh Pacific fish for sourcing our bioluminescent bacteria that we would use to create a glowing map of the city of Seattle. It was displayed on one of our handmade lab benches and when it got dark enough that evening, we shut off the lights and amazed our guests with a living map!
Summary
Naturally glowing bacteria can easily be found in the ocean. By incubating a marine fish (in our case, Pacific Herring), in a sea water broth, glowing bacteria like Vibrio fischeri can be isolated. These bioluminescent bacteria are “social” organisms and will only glow if there are enough of their “brothers and sisters” around. This regulation of gene expression in response to population density as coordinated behavior is called "quorum sensing", and these bacteria produce and release chemicals that induce the mechanism for creating light.
Methods
The fish were sourced from Uwajimaya (as all good fish are!). We chose pacific herring and rockfish because they were "fresh" (never-frozen) marine fish. (We learned at a later date that the rockfish was sourced from a channel rather than open ocean.) We incubated the fish for 48 hours in sterile sea water bought from a pet store. After incubation, we streaked seawater agar plates from the brightest areas of the fish. Conveniently, V. fischeri grow best around room temperature. To isolate the glowing bacteria, we did 3 rounds of incubating and replating bright colonies. This involved waiting in the dark until our eyes acclimated and circling glowing colonies by marking the backs of petri dishes. We spent a lot of time in the restroom (the only dark place in the lab!).
Conclusion
This was an amazing experience and piece of living art that our SoundBio team and community worked together to make happen. Thanks everyone!
- Regina Wu